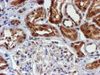

Cytochrome P450 17A1 (CYP17A1) Mouse Monoclonal Antibody [Clone ID: OTI3F11]
CAT#: TA503442
CYP17A1 mouse monoclonal antibody, clone OTI3F11 (formerly 3F11)
Size: 30 ul
Formulation: Carrier Free
USD 823.00
USD 436.00
Specifications
| Product Data | |
| Clone Name | OTI3F11 |
| Applications | FC, IHC, WB |
| Recommended Dilution | WB 1:2000, IHC 1:150, FLOW 1:100 |
| Reactivities | Human |
| Host | Mouse |
| Isotype | IgG1 |
| Clonality | Monoclonal |
| Immunogen | Full length human recombinant protein of human CYP17A1(NP_000093) peoduced in HEK293T cell. |
| Formulation | PBS (pH 7.3) containing 1% BSA, 50% glycerol and 0.02% sodium azide. |
| Concentration | 1 mg/ml |
| Purification | Purified from mouse ascites fluids or tissue culture supernatant by affinity chromatography (protein A/G) |
| Conjugation | Unconjugated |
| Storage | Store at -20°C as received. |
| Stability | Stable for 12 months from date of receipt. |
| Predicted Protein Size | 57.2 kDa |
| Gene Name | cytochrome P450 family 17 subfamily A member 1 |
| Database Link | |
| Background | This gene encodes a member of the cytochrome P450 superfamily of enzymes. The cytochrome P450 proteins are monooxygenases which catalyze many reactions involved in drug metabolism and synthesis of cholesterol, steroids and other lipids. This protein localizes to the endoplasmic reticulum. It has both 17alpha-hydroxylase and 17,20-lyase activities and is a key enzyme in the steroidogenic pathway that produces progestins, mineralocorticoids, glucocorticoids, androgens, and estrogens. Mutations in this gene are associated with isolated steroid-17 alpha-hydroxylase deficiency, 17-alpha-hydroxylase/17,20-lyase deficiency, pseudohermaphroditism, and adrenal hyperplasia. [provided by RefSeq, Jul 2008] |
| Synonyms | CPT7; CYP17; P450C17; S17AH |
| Reference Data | |
| Protein Families | Druggable Genome, P450 |
| Protein Pathways | C21-Steroid hormone metabolism, Metabolic pathways |
Documents
| Product Manuals |
| FAQs |
| SDS |
Resources
| Antibody Resources |
{0} Product Review(s)
Be the first one to submit a review






























































































































































































































































 Germany
Germany
 Japan
Japan
 United Kingdom
United Kingdom
 China
China